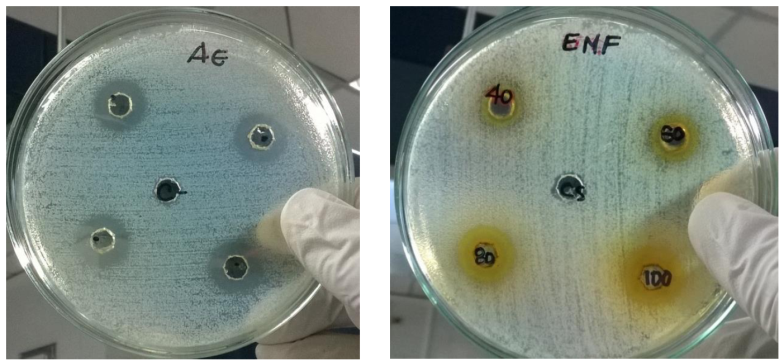

Serviços Personalizados
Journal
Artigo
Indicadores
-
 Citado por SciELO
Citado por SciELO -
 Acessos
Acessos
Links relacionados
-
 Similares em
SciELO
Similares em
SciELO
Compartilhar
Revista mexicana de ciencias agrícolas
versão impressa ISSN 2007-0934
Rev. Mex. Cienc. Agríc vol.9 no.5 Texcoco Jun./Ago. 2018
https://doi.org/10.29312/remexca.v9i5.1504
Articles
Extracts of Tagetes patula L. (Asteraceae): a bactericidal potential against Moko
1University of Quindío-Faculty of Health Sciences. Highway 15 North 12th Street, Colombia South America. Tel. 1 (57) 67359300. (eli.soto.2@hotmail.com; leyn-269@hotmail.com).
2Young researchers from Colciencias.
3Faculty of Basic Sciences and Technologies-Biology Program-Universidad del Quindío. (neloango@uniquindio.edu.co).
Ralstonia solanacearum race 2 is the cause of Moko or bacterial wilt, producing large economic losses in crops such as banana, tobacco and tomato. Several components of the extracts and essential oil (AE) of Tagetes patula L. have been described, including: benzofurans, carotenoids, flavonoids and thiophenes that are biologically active and potentially allelopathic against many pathogenic organisms. The investigations of the effect of the extracts and the AE of T. patula L., against R. solanacearum are scarce. The objective of this investigation was to analyze the antioxidant potential and determine the effect of the floral methanolic extracts (EMF) and leaves (EMH) and the AE on the growth of the bacteria. The T. patula EMF has a higher free radical scavenging capacity (DPPH) than the AE, possibly related to its higher phenol content. The EMF also has a high content of flavonoids and terpenoids. The chemical composition of the AE was determined by gas/mass chromatography, which revealed six major components, which represent more than 84% of the EA: Indane 5.47%, D-limonene 5.76%, Z-ocimene 5.98%, terpinolene 6.73%, Bervenona 19.98% and piperitone with 40.4%. The EMF as the AE inhibited the growth of R. solanacearum race 2, but the AE was more effective (radius of inhibition 16 cm). Based on these results EMF and AE of flowers and leaves of T. patula may be an option for control R. solanacearum race 2.
Keywords: Ralstonia solanacearum; Tagetes patula L.; antioxidant; essential oil; plant extracts
Ralstonia solanacearum raza 2 es la causante del Moko o marchitez bacteriana, produciendo grandes pérdidas económicas en cultivos como plátano, tabaco y tomate. Se han descrito varios componentes de los extractos y del aceite esencial (AE) de Tagetes patula L., que incluyen: benzofuranos, carotenoides, flavonoides y tiofenos que son biológicamente activos y potencialmente alelopáticos contra muchos organismos patógenos. Las investigaciones del efecto de los extractos y el AE de T. patula L contra R. solanacearum son escasas. El objetivo de esta investigación fue analizar el potencial antioxidante y determinar el efecto de los extractos metanólicos de flores (EMF) y de hojas (EMH) y el AE sobre el crecimiento de la bacteria. El EMF de T. patula posee mayor capacidad captadora de radicales libres (DPPH) que el AE, posiblemente relacionado con su mayor contenido de fenoles. También el EMF tiene un alto contenido en flavonoides y terpenoides. La composición química del AE fue determinada por cromatografía gas/masa, la cual reveló seis componentes mayores, los cuales representan más de 84% del AE: Indano 5.47%, D-limoneno 5.76%, Z-ocimeno 5.98%, terpinoleno 6.73%, Bervenona 19.98% y la piperitona con 40.4%. El EMF como el AE inhibieron el crecimiento de R solanacearum raza 2, pero el AE fue más efectivo (radio de inhibición 16 cm). Basados en estos resultados EMF y AE de flores y hojas de T. patula puede ser una opción para el control R solanacearum raza 2.
Palabras clave: Ralstonia solanacearum; Tagetes patula L.; aceite esencial; antioxidante; extractos vegetales
Introduction
Ralstonia solanacearum causes large economic losses to plantain, tobacco and tomato growers. The infection with this bacterium reduces the production in these crops through the damages it causes in the vascular system of the plant and consequently to all its parts (leaves, flowers, fruits, stems), leading to the disease known as Moko or bacterial wilt. The control of R. solanacearum is achieved mainly through the elimination of the crop and the subsequent quarantine of the soils, because very little has been achieved with synthetic bactericides due to the high survival capacity of the bacteria (Ceballos et al., 2014; Kheirandish and Harighi,), therefore, the use of plant extracts as control agents for this bacterium is a promising area of research, not only because of its low cost and safety for human health, but because it is environmentally friendly.
The genus Tagetes are annual perennial grasses, 20 to 30 cm tall, belonging to the Asteraceae family. This plant, originally from North and South America, but with a wide global distribution, is used in traditional medicine in many regions of the world. There are about 30 species of Tagetes, the most studied are T. patula, T. minuta and T. erecta (Xu et al., 2012). As a result of these studies, several components of its extracts and essential oil have been described, including: benzofurans, carotenoids, flavonoids and thiophenes such as: terpineol, (Z)-ocimeno, dihydrotagetone, (E)-ocimenone, (Z)-tagestone, and (Z) ocimenone, piperitone, which are biologically active and potentially allelopathic against many pathogenic organisms such as fungi, bacteria, nematode viruses, insects, ticks among others (Hooks et al., 2010; Andreotti et al., 2013; Politi et al., 2016). However, the role of these compounds has not been fully characterized against R. solanacearum, given that the control of this bacterium is problematic, there is a need to find new control strategies. Based on the phytochemistry described in recent studies of T. patula L., such as its richness in flavonoids and terpenoids and its biocidal potential, the present investigation was aimed at. 1) analyze the antioxidant potential of the extracts and the AE of T. patula; and 2) determine the effect of extracts and AE on the growth of R. solanacearum.
Materials and methods
Vegetal material
Fresh Tagetes patula L. flowers were collected from plants planted at the The Alsacia, Buenavista, Quindío farm (4° 21’ 35’’ north latitude - 75° 44’ 21’’ west longitude, 1 450 m central mountains), the taxonomic determination was made and a specimen was deposited in the herbarium of the University of Quindio (HUQ) (record # 36926, code # 12929).
Preparation of extracts
The plant material (leaves and flowers) was washed and dried in an oven at 40 °C and then pulverized.
The methanolic extracts of leaves (EMH) and flowers (EMF) dried and pulverized of T. patula, were obtained by continuous percolation with anhydrous methanol for two weeks, the solution was filtered and concentrated using a rotaevaporator (Heydolf brand), finally they were lyophilized until reaching a humidity of approximately 5%.
The chlorophylls of the EMH, were separated by the action of an Ethanol-Water mixture that allows to precipitate them, the obtained solution was filtered under vacuum and concentrated in a rotary evaporator under reduced pressure and at a temperature of 38 °C. This extract was lyophilized until obtaining an extract with approximately 5% humidity.
Phytochemical analysis of T. patula extracts
The EMH and the EMF were evaluated for the identification of tannins, saponins, flavonoids, quinones, sterols, triterpenoids, naphthoquinones and anthraquinones, cardiotonic glycosides, terpene lactones and alkaloids following standard identification methods (Carvajal-Rojas et al., 2009).
DPPH antioxidant activity
The antioxidant activity was determined by the uptake of free radicals of 1,1-diphenyl-2-picrilhydrozyl (DPPH˙) applying the methodology described by Guha et al. (2010 and 2011). Different concentrations of the extracts of T. patula, EM (35, 25, 15, 8, 4, 2 μg mL-1), prepared in methanol, and AE (3, 2.6, 2.1, 1.7, 0.9, 0.65 mg mL-1). The extracts reacted with DPPH for 30 min in the dark, then read at 517 nm in spectrophotometer genesis 5. The calculation of the antioxidant activity was carried out with the formula: antioxidant activity (%)= (control-sample)/(control)*100.
Determination of total phenols
The Folin-Ciocalteu Stagos et al. (2012) was used to determine the total phenolic content of the extracts, with gallic acid as a standard sample. For each sample 1 mg/ml of each extract was used, all the tests were carried out in triplicate and the results are expressed as mg of gallic acid/g of extract (mg AG g-1).
Obtaining and analysis of the essential oil of T. patula
The extraction of the essential oil (AE) was carried out by steam distillation according to some modifications to the method of Leal and collaborators Torres et al. (2013), briefly: 3 kg of leaves and flowers (50:50 of fresh leaves and flowers), were subjected to a steam distillation process (temperature ± 100 °C), to obtain the compounds volatile the condenser was maintained between 0 and 4 °C. The essential oil was separated, by the liquid-liquid extraction method, with ethyl acetate which was removed by rotaevaporation. The essential oil was kept in an amber bottle and in refrigeration, for further analysis.
Determination of essential oil components
It was carried out in a gas chromatograph coupled to a mass spectrometer (CG/EM) zhimadzu, model GC: autosystem. TemXL, MS: turbo plus under the following conditions: Rtx©-5 column of 30 m long, diameter 0.25 μ, injection temperature: 240 °C, injection volume: 5 μL. The detection of the chemical components was by comparison with the mass spectral standards of the respective libraries. The relative percentage of the individual compounds was determined based on the normalization method of the area under the peak using correction factors.
Antibacterial activity
Strains of Ralstonia solanacearum race 2
Strains were isolated from plant material (Dominico harton banana fruits) infected with Moko and identified as Ralstonia solanacearum race 2 by morphological comparison and molecular biology, with a control strain R. solanacearum race 2 CIAT 1040 provided by the International Center for Tropical Agriculture (CIAT) Palmira-Colombia.
For all the tests of antimicrobial activity the method of diffusion in agar was used (Montiel et al., 2016), the method is based on the diffusion of the essential oil in solid medium around the excavation of 6 mm made with a punch. Initially the standard inoculum was prepared, a roast was taken from the culture of R. solanacearum race 2 and it was suspended in 5 mL of sterile saline until reaching the turbidity of 0.5 of the Mc Farland scale equivalent to 11.5x109 UFC mL-1. This inoculum was distributed on the solid agar carefully with a sterile swab, after 15 min of fixation of the microorganisms in the agar the perforations were made with the punch and 25 μL of the essential oil was added.
In addition, different concentrations of T. patula methanolic extracts of 40, 60, 80 and 100 mg mL-1 were tested on separate plates. The 25 μL of each concentration was added to the 6 mm excavations. Plates were incubated at 30 °C. The antimicrobial effect was given by the diameter of the zone of inhibition.
Results and discusión
Phytochemical analysis of T. patula extracts
The preliminary phytochemical analysis of the EMH and EMF extracts showed the presence of some secondary metabolites, such as tannins, saponins, flavonoids, terpenes, quinones, sugars and others described in Table 1.
Table 1 Phytochemical analysis of the methanolic extracts of T. patula L.
| Metabolite | EMH | EMF |
|---|---|---|
| Tannins | + | +++ |
| Flavonoids | ++ | +++ |
| Quinones | - | ++ |
| Cardiotonic | - | - |
| Deoxiazucares | + | + |
| Sugars | ++ | +++ |
| Coumarins, terpene lactones | ++ | ++ |
| Steroids and triterpenoids | + | ++ |
EMH= methanolic extract of leaves; EMF= floral methanolic extract; += presence; -= absence.
The most abundant compounds for the methanolic extract of leaves were flavonoids, sugars and coumarins, terpene lactones, for the flowers were tannins, flavonoids and sugars.
The secondary metabolites found in this work in the methanolic extracts of leaves and flowers of T. patula, have also been identified by other authors, for example, in this plant, more than twelve flavonoids have been described, such as quercetagestin and its derivatives, kaempferol, kaempferitrin and its derivatives, myricetin and its derivatives, patuletin, and lutein, among others. Also steroids such as β-sitosterol and cholesterol (Xu et al., 2012). Many of these compounds show a high potential to be included as new medicines or as pesticides (Raut and Karuppayil, 2014; Politi et al., 2016). Also other applications as its antioxidant activity, emerge gradually from the studies of the compounds of Tagetes spp. (Raut and Karuppayil, 2014).
The gas-mass chromatography of the essential oil of leaves and flowers allowed to make a more detailed identification of some of these compounds and their properties as described below.
DPPH antioxidant activity
The EMF had the highest DPPH free radical scavenging capacity, thus: 35 μg mL-1 EMF, captured 89.52%, 120 μg mL-1 EMH 85.95% and 3 mg mL-1 AE (42.41%). The concentration that has 50% uptake of DPPH radicals was established for the EMF at 13.21 μg mL-1 and for the EMH: 52.85 mg mL-1: for the essential oil it was not possible to establish it, since its concentration was not comparable with the standard.
Determination of total phenols
The EMF exhibited the highest phenolic content with 227.67 μg Eq- of gallic acid/mg of EMF, followed by EMH with 153.48 μg Eq- of gallic acid/mg of EMH, while the AE of flowers and leaves had the lowest content phenolic with 14.44 g Eq- of gallic acid/mg of AE.
Different works relate the content of phenolic compounds (including flavonoids) in plants with their ability to eliminate free radicals (Al Dhaheri et al., 2013). In this study, a relationship was found between the phenolic content of the extracts and their capacity to capture free radicals, since the extracts with higher phenolic content were found to have a higher DPPH free radical uptake capacity. On the other hand, authors have shown high values of antioxidant activity of the genus Tagetes (Kazibwe et al., 2017).
Furthermore, it has been shown that different allelochemical compounds with potential antioxidant activity are not only involved in the defense mechanisms of the plant, but may be responsible for the cytotoxic activity observed in this genus (Politi et al., 2016); as evidenced by the results against R. solanacearum, which are described below. However, more studies are needed on the cytotoxicity of these compounds and their antioxidant capacity.
Components of T. patula essential oil
Steam distillation of T. patula flowers gave 1 ml kg-1 of essential oil. The qualitative and quantitative analysis of the same, performed by gas-mass chromatography allowed the identification of twenty compounds (Figure 1).
The major components were six, in ascending order: Indane 5.47%, D-limonene 5.76%, Z-ocimeno 5.98%, terpinolene 6.73%, Bervenona 19.98% and piperitone with 40.4%, representing these six 84.02% of the components identified, which are described in Table 2.
Table 2 Chemical composition of the essential oil of leaves and flowers of Tagetes patula, expressed as percentages.
| Number Peak |
Retention time |
Compounds | Synonyms | Abundance (%) |
|---|---|---|---|---|
| 1 | 5.233 | Butyl ester | N -butyl acetate | 3.62 |
| 2 | 6.503 | 2- hexanal | (E) -2-hexenal | 0.81 |
| 3 | 6.76 | 3- hexen- 1- ol | Cis-3-hexenol | 1.31 |
| 4 | 7.173 | 2- hexen- 1-ol | (E) -2-hexenol | 0.39 |
| 5 | 7.301 | 1-hexanol | Hexyl alcohol | 0.57 |
| 6 | 7.527 | 1-butanol, 3-methyl-acetate | Isoamyl acetate | 0.1 |
| 7 | 7.619 | 1-butanol 2-methyl-acetate | 1-2-methylbutanol acetate | 0.23 |
| 8 | 11.006 | Betaphellandrene | Phellandrene | 0.48 |
| 9 | 11.737 | Beta- myrcene | Mirceno | 0.59 |
| 10 | 12.313 | 3-Hexen-1-ol | Cis-3-hexenol | 0.42 |
| 11 | 13.048 | D- limonene | Limonene | 5.76 |
| 12 | 13.404 | Trans-beta-ocimene | Trans- β- ocimene | 1.98 |
| 13 | 13.804 | 1,3,6-octadien-3-ol, | Z- ocimene | 5.98 |
| 14 | 15.075 | 1- methyl-4- (1-methylethylidene) | Terpinolene | 6.43 |
| 15 | 15.468 | 1, 6-octadien-3-ol | Linalool | 1.84 |
| 16 | 17.81 | Terpinen-4-ol | Terpinen-4-ol | 1.37 |
| 17 | 20.604 | 2- cyclohexen-1-one | Piperitone | 40.4 |
| 18 | 21.501 | Indane | Indane | 5.47 |
| 19 | 22.858 | 2- pinen- 4-one | Verbenone | 19.98 |
| 20 | 24.68 | Caryophyllene | Caryophyllene | 2.27 |
Similar compounds were described by Prakash et al. (2012), for the inflorescences of Tagetes patula, they found that the major components of the essential oil of this variety were: 1.8-cineola (4.4%), (Z)-Beta-ocimene (11.8%), terpinolene (6.9%), (Z)-ocimenone (6.4%), (E)-ocimenone (3%), gamma-elemeno (16.9%), piperitenone (3.3%), β-caryophyleno (18.6%) and (E)-β-ionone (2.5%). Very similar to those found in this work, but in lower percentages such as piperitone. Also Kyarimpa et al. (2014), in Tagetes minuta essential oil, identified nine major components, three of which coincide with those identified as major in the present work, namely limonene 8%, Beta-trans ocimene 15.9% and verbenone 16.8%.
These differences in components and the relative percentages may be due to environmental and stationary factors related to the cultivation of the plants, to the geographical location, to the part of the plant used, to the species itself (T. patula, T. erecta, T. minuta), to the amount of fresh material, to the extraction systems, although these are very similar and to the amount of irrigation as has been described by Umar et al. (2017) for T. patula and T. erecta, subjected to different irrigation deficit strategies. They found that components of essential oils such as caryophyllene, terpinolene, and others, can increase in states of stress due to water deficit in different species of Tagetes.
Antibacterial activity
Once obtained the methanolic extracts and the essential oil its antibacterial effect was tested against R. Solanacerum race 2.
Ralstonia solanacearum race 2 (Smith, 1896) is a Gram-negative bacterium in the form of a bacillus that produces Moko disease or bacterial wilt, which affects the vascular system of plants such as banana, banana, tobacco and tomato, among others. The Moko has caused great damage to the cultivars of potatoes, tobacco, bananas and bananas in the world.
Many strategies have been proposed to combat Moko, including cultivating resistant varieties and transgenic plants, or the use of pesticides of natural or chemical origin (Ceballos et al., 2014; Liu et al., 2016), but all of them with limited success, due to the ability to survive in complex environments, wide range of hosts, wide geographic distribution and genetic diversity of R. solanacearum (Ceballos et al., 2014; Kheirandish and Harighi, 2015).
The results of the present study show that the EMH does not possess antibacterial activity against R. solanacearum, while the EMF showed a concentration-dependent inhibition, but R. solanacearum race 2, proved to be very sensitive to the AE of T. patula. The diameters for the inhibition zones are shown in Table 3 and Figure 2.
Table 3 Antibacterial activity of T. patula extracts against Ralstonia solanacearum race 2.
| Concentration (mg mL-1) |
Halo bacterial inhibition of EMF (mm) |
Results |
|---|---|---|
| 40 | 10 | Limit sensitivity (sensitive = +) |
| 60 | 11 | Limit sensitivity (sensitive = +) |
| 80 | 15 | Average (very sensitive = ++) |
| 100 | 16 | Average (very sensitive = ++) |
| Concentration in (%) | Bacterial inhibition halo of AE (mm) | Results |
| 100 | 16 | Average (very sensitive = ++) |
Figure 2 Halves of inhibition of the essential oil (AE) and the methanolic extract of flowers (EMF) against Ralstonia solanacearum race 2.
In this regard, there are several studies that demonstrate the fungicidal, larvicidal and insecticidal capacity of the essential oil of the Tagetes genus (Hooks et al., 2010; Andreotti et al., 2013; Politi et al., 2016). Also other studies with extracts from different plants other than the Tagetes genus have shown an antibacterial effect against R. solanacearum, thus Bay et al. (2016), demonstrated that eugenol, a compound of the ethanolic flower extract of Syringa oblata, significantly inhibits the growth of R. solanacearum (18.5 mm inhibition radius). Very similar to the inhibition radius found in our work (diameter 16 mm with the AE). Similarly, Li and collaborators (Li et al., 2014) using Lansiumamide B, which is isolated from Clausena lansium seeds, showed that this compound completely inhibits the growth of R. solanacearum at a concentration of 125 mg/L in vitro. These and other studies show the sensitivity of R. solanacearum to different compounds of plant origin.
In this research and for the first time as far as is known, the antibacterial effect of the methanolic extract of flowers and the essential oil of T. patula against R. solanacearum race 2 is described. T. patula (Asteraceae) is an annual perennial herb belonging to the family of the Asteraceae. Some components of the extracts and the essential oil of T. patula have been previously described (Prakash et al., 2012; Xu et al., 2012; Politi et al., 2016), these components are similar to those found in the present. Study as already mentioned. These compounds are biologically active and potentially allelopathic against various pathogens.
Although the role of each of the compounds has not been fully identified, it was observed, for example, that flavonoids and terpenoids have potent anti-bacterial activity, these results show that the methanolic extract of flowers and the essential oil of T. patula , are rich in flavonoids and terpenoids, of the latter the piperitone and verbenone were the most abundant in the essential oil (40.4 and 19.98% respectively), these compounds have been attributed an important antimicrobial activity, specifically bactericidal, thus Brahmi and collaborators found that the main component of the essential oil of Mentha rotundifolia L. was the epoxide of trans-Piperitone (30.2%) and the piperitone oxide (8.7%) and this essential oil achieved the inhibition of the growth of various bacteria (Escherichia coli and Pseudomonas aeruginosa) among others (Brahmi et al., 2016). While Scollard et al. (2016), it was found that verbenone inhibits the growth of Listeria monocytogenes.
However, in the present study the effect of these individual compounds was not evaluated, so it can only be suggested that such components or a mixture of them may be responsible for the inhibition capacity of R. solanacearum, indicating the need to continue deepening in the components of the essential oil and its effects on this bacterium.
Conclusions
The EMF has the highest free radical scavenging capacity (DPPH) compared to the AE possibly related to its higher content of phenols, which shows it as a potential candidate to develop drugs against oxidative stress. The methanolic extract of T. patula flowers has a high content of flavonoids and terpenoids. While the composition of the essential oil of leaves and flowers showed a high content of piperitone and verbenone. Both EMF and AE inhibited bacterial growth, but AE was more effective. Based on the results of this work, the methanolic extract of flowers and essential oil of flowers and leaves of T. patula may be an option for the control R. solanacearum race 2.
Acknowledgments
This work was funded by the Ad ministrative Department of Science and Technology of Colombia (Colciencias), the Inter-American Development Bank (IDB) contract # 1113-545-31135, RC 551 of 2012 and the University of Quindio (internal project # 582) and the program of young researchers of Colciencias 2014.
REFERENCES
Al Dhaheri, Y.; Eid, A.; AbuQamar, S.; Attoub, S.; Khasawneh, M.; Aiche, G. and Iratni, R. 2013. Mitotic arrest and apoptosis in breast cancer cells induced by Origanum majorana extract: upregulation of TNF-α and downregulation of survivin and mutant p53. PLoS ONE. 8(2):1-14. [ Links ]
Andreotti, R.; Garcia, M. V.; Cunha, R. C. and Barros, J. C. 2013. Protective action of Tagetes minuta (Asteraceae) essential oil in the control of Rhipicephalus microplus (Canestrini, 1887) (acari: ixodidae) in a cattle pen trial. Veterinary Parasitol. 197(1-2):341-345. [ Links ]
Bai, W.; Kong, F.; Lin, Y. and Zhang, C. 2016. Extract of Syringa oblata: a new biocontrol agent against tobacco bacterial wilt caused by Ralstonia solanacearum. Pesticide Biochem. Physiol. 134:79-83. [ Links ]
Brahmi, F.; Abdenour, A.; Bruno, M.; Silvia, P.; Alessandra, P.; Danilo, F. and Mohamed, C. 2016. Chemical composition and in vitro antimicrobial, insecticidal and antioxidant activities of the essential oils of Mentha pulegium L. and Mentha rotundifolia L. Huds growing in Algeria. Industrial Crops and Products. 88:96-105. [ Links ]
Carvajal-Rojas, L.; Hata-Uribe, Y.; Sierra-Martinez, N. and Rueda-Niño, D. 2009. Preliminart phytochemical analisis of Cupatá (Strycnos schultesiana Krukoff) stems and seeds. Rev. Colombia Forestal. 12:161-170. [ Links ]
Ceballos, G.; Álvarez, E. y Bolaños, M. M. 2014. Reducción de poblaciones de Ralstonia solanacearum raza 2 (Smith) en plátano (Musa AAB Simmonds) con aplicación de extractos de Trichoderma sp. (Alexopoulus y Mims) y bacterias antagonistas. Acta Agron. 63(1). [ Links ]
Guha, G.; Rajkumar, V.; Ashok Kumar, R. and Mathew, L. 2010. Aqueous extract of Phyllanthus amarus inhibits chromium(VI)-induced toxicity in MDA-MB-435S cells. Food and Chemical Toxicology. Inter. J. Published British Ind. Biol. Res. Association. 48(1):396-401. [ Links ]
Hooks, C. R. R.; Wang, K.-H.; Ploeg, A. and McSorley, R. 2010. Using marigold (Tagetes spp.) as a cover crop to protect crops from plant-parasitic nematodes. Appl. Soil Ecol. 46(3):307-320. [ Links ]
Kazibwe, Z.; Kim, D.-H.; Chun, S. and Gopal, J. 2017. Ultrasonication assisted ultrafast extraction of Tagetes erecta in water: cannonading antimicrobial, antioxidant components. J. Mole. Liquids. 229:453-458. [ Links ]
Kheirandish, Z. and Harighi, B. 2015. Evaluation of bacterial antagonists of Ralstonia solanacearum, causal agent of bacterial wilt of potato. Biol. Control. 86:14-19. [ Links ]
Kyarimpa, C. M.; Böhmdorfer, S.; Wasswa, J.; Kiremire, B. T.; Ndiege, I. O. and Kabasa, J. D. 2014. Essential oil and composition of Tagetes minuta from Uganda. Larvicidal activity on Anopheles gambiae. Industrial Crops and Products . 62:400-404. [ Links ]
Li, L.; Feng, X.; Tang, M.; Hao, W.; Han, Y.; Zhang, G. and Wan, S. 2014. Antibacterial activity of Lansiumamide B to tobacco bacterial wilt (Ralstonia solanacearum). Microbiol. Res. 169(7-8):522-526. [ Links ]
Liu, L.; Sun, C.; He, X.; Liu, X.; Wu, H.; Liu, M. and Zhang, Y. 2016. The secondary compost products enhances soil suppressive capacity against bacterial wilt of tomato caused by Ralstonia solanacearum. Eur. J. Soil Biol. 75:70-78. [ Links ]
Politi, F. A. S.; Queiroz-Fernandes, G. M.; Rodrigues, E. R.; Freitas, J. A. and Pietro, R. C. L. R. 2016. Antifungal, antiradical and cytotoxic activities of extractives obtained from Tagetes patula L. (Asteraceae), a potential acaricide plant species. Microbial Pathogenesis. 95:15-20. [ Links ]
Prakash, O.; Rout, P. K.; Chanotiya, C. S. and Misra, L. N. 2012. Composition of essential oil, concrete, absolute and SPME analysis of Tagetes patula capitula. Industrial Crops and Products . 37(1):195-199. [ Links ]
Raut, J. S. and Karuppayil, S. M. 2014. A status review on the medicinal properties of essential oils. Industrial Crops and Products . 62:250-264. [ Links ]
Scollard, J.; McManamon, O. and Schmalenberger, A. 2016. Inhibition of Listeria monocytogenes growth on fresh-cut produce with thyme essential oil and essential oil compound verbenone. Postharvest Biol. Technol. 120:61-68. [ Links ]
Stagos, D.; Portesis, N.; Spanou, C.; Mossialos, D.; Aligiannis, N.; Chaita, E. and Kouretas, D. 2012. Correlation of total polyphenolic content with antioxidant and antibacterial activity of 24 extracts from Greek domestic Lamiaceae species. Food Chem. Toxicol. 50(11):4115-4124. [ Links ]
Torres, E. L.; Vigil, A. L.-M. y Morales, M. E. S. 2013. Extracción, composición y caracterización de los aceites esenciales de hoja y semilla de cilantro (Coriandrum sativum). Temas Selectos de Ingeniería en Alimentos. 7(1):97-103. [ Links ]
Umar, S.; Sharma, M. P.; Khan, W. and Ahmad, S. 2017. Variation in ornamental traits, physiological responses of Tagetes erecta L. and T. patula L. in relation to antioxidant and metabolic profile under deficit irrigation strategies. Sci. Hortic. 214:200-208. [ Links ]
Xu, L.; Chen, J.; Qi, H. and Shi, Y. 2012. Phytochemicals and their biological activities of plants in Tagetes L. Chinese Herbal Medicines. 4(2):103-117. [ Links ]
Received: April 2018; Accepted: July 2018











 texto em
texto em 



